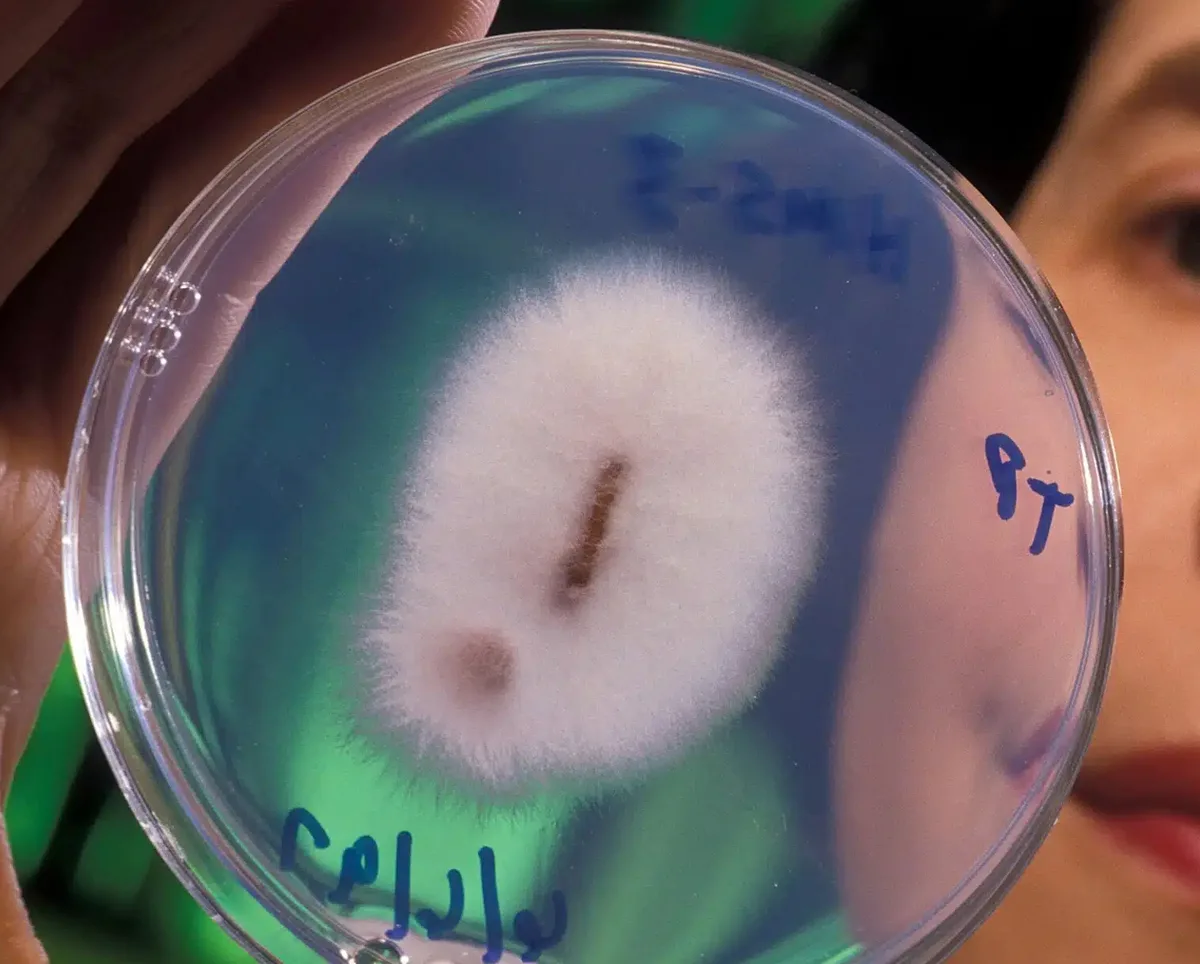
ciuperca aur

O banală ciupercă din sol, recunoscută mai ales pentru faptul că distruge culturile agricole, ascunde un secret uluitor: atrage și asimilează metalele prețioase. Cercetătorii australieni au descoperit că ciuperca Fusarium oxysporum extrage aurul din mediul înconjurător pentru a-l folosi ca pe o armură, o abilitate complet neobișnuită ce atrage acum atenția industriei de prospectare minieră și a experților în explorare spațială.

Pentru majoritatea absolută a organismelor vii, aurul nu prezintă niciun interes. Din punct de vedere chimic, este complet inofensiv și inert, așa că viața, în general, îl ignoră. Mai puțin oamenii, mulți fiind dispuși să facă orice pentru a pune mâna pe el. Totuși, o ciupercă obișnuită din sol a „spart” acest cod chimic, găsind o modalitate prin care nu doar că asimilează metalul prețios, dar îl și poartă pe post de armură.
În anul 2019, cercetătorii de la CSIRO, agenția națională de știință din Australia, au făcut o descoperire uluitoare: o banală ciupercă de sol, cunoscută sub numele de Fusarium oxysporum, este capabilă să dizolve particulele de aur din mediul său înconjurător pentru ca, ulterior, să se acopere cu ele. Faptul i-a luat prin surprindere pe oamenii de știință tocmai din cauza naturii inerte a aurului, un metal care interacționează extrem de rar cu biologia.
Această descoperire nu este o simplă curiozitate de laborator. Transformarea unui metal inert într-un scut biologic deschide calea către tehnici de extracție minieră neinvazivă și ar putea reduce drastic costurile uriașe ale forajelor tradiționale.
Iar această armură aurie nu este doar o bizarerie estetică. Ciupercile care interacționează cu aurul cresc, de fapt, mai mult și se răspândesc mult mai rapid comparativ cu suratele lor lipsite de acest „bling” natural. Conform datelor CSIRO, acest avantaj biologic major o face să aibă un succes mult mai mare în mediul ei, reușind totodată să susțină în jurul său o comunitate mult mai diversă de alte ciuperci.
Mecanismul din spate este un proces ingenios în două etape. Inițial, ciuperca oxidează și dizolvă aurul aflat în mediul înconjurător. Ulterior, precipită acest aur dizolvat înapoi sub formă de particule solide, pe care le atașează ferm de filamentele sale. Așa cum subliniază transcrierea oficială a CSIRO, aceasta a reprezentat prima dovadă concretă că ciupercile joacă un rol activ în ciclul aurului la suprafața planetei noastre.
Cum extrage ciuperca Fusarium aurul din mediul înconjurător?
Partea și mai fascinantă este că Fusarium oxysporum nu este vreo formă de viață exotică, izolată în adâncurile unei singure mine. Wikipedia o clasifică drept o ciupercă de sol extrem de răspândită. Aceasta prezintă numeroase tulpini care acționează ca saprofite sau endofite — fie complet inofensive, fie de-a dreptul benefice. Pe de altă parte, alte tulpini sunt recunoscute în agricultură ca fiind agenți patogeni severi pentru plante.
Acest context vast face ca rezultatul legat de aur să fie cu atât mai spectaculos: cercetătorii analizau un organism absolut familiar, care prezenta un comportament profund neobișnuit în prezența unui metal care rezistă, în mod normal, oricăror schimbări chimice.
Momentul „Evrika” a avut loc în Boddington, Australia de Vest, o zonă faimoasă pentru zăcămintele sale aurifere. Dr. Tsing Bohu, cercetătorul principal al studiului condus de CSIRO, a explicat clar că această interacțiune este „neobișnuită și surprinzătoare”, luând în calcul lipsa de reactivitate chimică a aurului. Pe scurt, ciuperca face un lucru pe care marea majoritate a formelor de viață nu îl pot face: transformă un metal inert într-un activ din punct de vedere biologic.

De ce au pus ochii companiile miniere pe Fusarium oxysporum
Având în vedere că Australia este al doilea cel mai mare producător de aur de pe glob, giganții din industria minieră au devenit extrem de atenți la aceste detalii. Miza nu este, evident, să „cultivăm” ciuperci pentru a recolta aur din ele. În schimb, companiile doresc să folosească Fusarium oxysporum pe post de instrument natural de prospectare.
Logica e simplă: analizând solul pentru a detecta anumite tulpini specifice ale acestei ciuperci, geologii ar putea localiza cu precizie zăcăminte promițătoare de aur ascunse în adâncuri. Această abordare organică urmează aceeași linie de succes demonstrată anterior de CSIRO: în regiunea Kalgoorlie (Australia de Vest), s-a dovedit că arborii pot absorbi aurul pentru a-l depozita direct în frunze, iar termitele pot integra particule de aur în mușuroaiele lor. Toate aceste descoperiri se concentrează pe același obiectiv major: detectarea semnalelor de la suprafață care ne trădează ce se află sub pământ.
Avantajele pentru sectorul minier sunt uriașe. Metodele tradiționale de explorare sunt notoriu de costisitoare, lente și devastatoare pentru mediul înconjurător. Utilizarea unui indicator biologic care să restrângă perimetrele de foraj sau zonele de prelevare de probe ar diminua drastic perturbarea inutilă a ecosistemelor și ar crește rata de succes în găsirea minereului. Prospectarea fungică ar putea înlocui, practic, forarea oarbă a sute de găuri de testare, transformând explorarea într-un proces mult mai ieftin și mai puțin invaziv.
Din solul australian, direct pe asteroizi?
Totuși, partea care a stârnit cel mai mult entuziasm din acest val reînnoit de interes se leagă de mineritul spațial. Un articol al publicației Mother Jones susține că mai multe companii și echipe de cercetători analizează un potențial imens în utilizarea microorganismelor (inclusiv a ciupercilor) pentru prelucrarea minereurilor în medii extreme, unde echipamentele convenționale de minerit ar fi inutile. Țintele principale? Asteroizii și alte corpuri cerești. Acest concept vizionar este denumit în articol mineralogie metabolică.
Trebuie, însă, să privim aceste speculații cu o doză de realism. Transcrierea oficială a celor de la CSIRO nu aduce în discuție niciun fel de planuri operaționale pentru mineritul spațial și nicio misiune pe asteroizi. Scopul lor științific a fost strict legat de explorarea sustenabilă și ciclul aurului pe Pământ. Așadar, scenariul spațial trebuie tratat ca o extensie speculativă, nu ca o aplicație deja demonstrată de experții CSIRO.
Dar asta nu înseamnă că ideea este absurdă. O ciupercă capabilă să interacționeze cu un metal greu prin mecanisme auto-organizate și cu un consum energetic extrem de redus este exact profilul biologic ideal pentru a extrage resurse în locuri în care metodele clasice ar eșua. Aceeași capacitate care îi permite lui Fusarium oxysporum să proceseze aurul terestru ar putea, teoretic, să fie adaptată pentru vidul spațial, chiar dacă, în acest moment, nicio companie nu a trimis încă vreo ciupercă pe un asteroid.

Latura întunecată a ciupercii aurifere
Ar fi o greșeală să privim Fusarium oxysporum doar ca pe o simplă curiozitate utilă mineritului. Specia ascunde o istorie ecologică complexă și uneori devastatoare. Deși o regăsim în solurile din toată lumea, de la arida tundră arctică până în deșertul Sonora, și deși majoritatea tulpinilor sunt parteneri banali ai plantelor, anumite tulpini sunt inamici agricoli redutabili.
Această ciupercă este responsabilă pentru ofilirea Fusarium, o afecțiune extrem de gravă care atacă peste 100 de specii de plante, printre care pepenii, roșiile și bananele. În contextele agricole, poate decima complet recoltele. Mai mult, a fost intens studiată ca un potențial micoerbicid. La un moment dat, guvernul din Columbia, aflat sub presiunea Statelor Unite, a luat în calcul utilizarea unei tulpini specifice a acestei ciuperci pentru eradicarea dirijată a culturilor de coca.
În România, infecția este cunoscută sub numele de fuzarioză, o boală vasculară temută de agricultori care ofilește rapid culturile de tomate, castraveți sau pepeni din sere și solarii, necesitând adesea rotația strictă a culturilor.
Această natură duală ridică semne mari de întrebare pentru orice viitoare aplicație practică. Lansarea lui Fusarium oxysporum pe scară largă pentru minerit spațial sau prospectare terestră va necesita măsuri stricte de biosecuritate și control, pentru a evita dezastre ecologice neintenționate, mai ales în zonele vulnerabile care depind de agricultură.
De ce ne fascinează atât de mult?
O mare parte din magia acestei descoperiri stă tocmai în contrastul uriaș dintre organisme și elemente: Fusarium oxysporum este o formă de viață dintre cele mai comune, în timp ce aurul este unul dintre cele mai nereactive metale de pe planetă. Faptul că o ciupercă oarecare a evoluat suficient cât să manipuleze un astfel de element până la punctul în care se acoperă cu el pare aproape de necrezut. Acesta este și motivul pentru care subiectul refuză să dispară din articolele de popularizare a științei.
Dincolo de bizarerie, descoperirea face parte dintr-o schimbare de paradigmă mult mai mare în explorarea resurselor: folosirea sistemelor biologice vii ca senzori naturali de ultimă generație, înlocuind excavarea brută, tehnologică. Exemplele cu ciupercile, termitele sau copacii studiate de CSIRO ne arată viitorul: știința se folosește acum de semnalele naturii pentru a descifra misterele ascunse în adâncurile pământului, cu mult înainte de a începe să săpăm o mină.
Așadar, înainte de a trimite utilaje masive pe asteroizi sau de a fora orbește la mare adâncime, soluția pentru viitorul resurselor ar putea veni de la același microorganism pe care, până acum, ne-am străduit doar să îl eradicăm din solarii.












